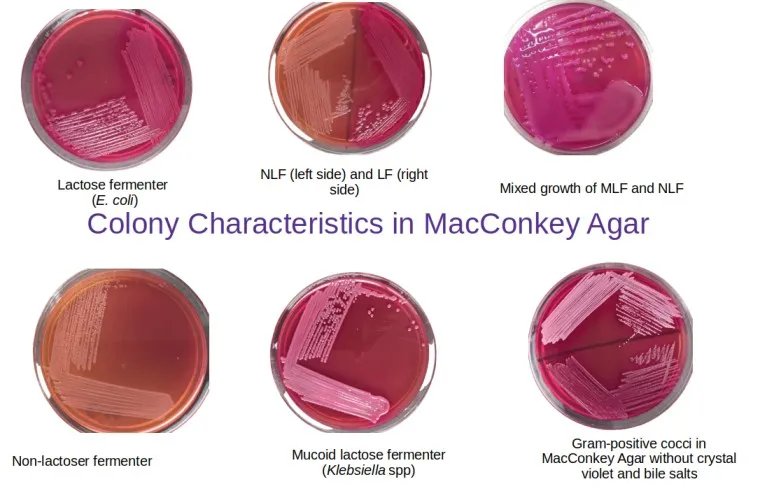

Media MacConkey Agar (MCA): Komposisi, Cara Pembuatan, Prosedur & Interpretasi Hasil
MacConkey Agar (MCA) adalah salah satu media kultur yang paling sering digunakan dalam laboratorium mikrobiologi klinik maupun pangan. Media ini diklasifikasikan sebagai media selektif dan diferensial. Sifat selektifnya berfungsi untuk menumbuhkan bakteri Gram-negatif dan menghambat pertumbuhan bakteri Gram-positif, sedangkan sifat diferensialnya digunakan untuk membedakan bakteri yang mampu memfermentasi laktosa (seperti Escherichia coli) dan yang tidak memfermentasi laktosa (seperti Salmonella dan Shigella).
Table Of Content
Prinsip dan Komposisi Media
Sebelum masuk ke tahap pembuatan, penting untuk memahami fungsi dari setiap komposisi bahan agar tidak terjadi kesalahan interpretasi. Warna merah muda atau netral pada media ini diatur oleh indikator pH.
| Komposisi | Jumlah (g/L) | Fungsi |
|---|---|---|
| Peptone (Pancreatic digest of gelatin) | 17.0 g | Sumber nitrogen dan nutrisi dasar. |
| Proteose Peptone (Meat & Casein) | 3.0 g | Sumber vitamin dan faktor pertumbuhan. |
| Laktosa (Lactose) | 10.0 g | Substrat karbohidrat untuk fermentasi. |
| Garam Empedu (Bile Salts No. 3) | 1.5 g | Agen selektif (menghambat Gram-positif). |
| Natrium Klorida (NaCl) | 5.0 g | Menjaga keseimbangan osmotik. |
| Neutral Red | 0.03 g | Indikator pH (Merah: Asam, Kuning/Bening: Basa). |
| Crystal Violet | 0.001 g | Agen selektif (menghambat Gram-positif tertentu). |
| Agar | 13.5 g | Bahan pemadat. |
| Total Padatan | ± 50.0 g | (Dapat bervariasi tergantung merek). |
Alat dan Bahan
- Bubuk media MacConkey Agar (misalnya merk Merck, Oxoid, atau Himedia).
- Aquades (air suling).
- Erlenmeyer.
- Timbangan analitik dan kertas timbang/kaca arloji.
- Hot plate stirrer (pemanas) dan batang pengaduk magnetik.
- Autoklaf.
- Cawan petri steril.
Prosedur Pembuatan
Berikut adalah langkah kerja standar pembuatan media MCA untuk volume 1 liter (1000 ml). Catatan: Selalu cek instruksi pada kemasan botol media karena gramasi bisa sedikit berbeda antar produsen.
1. Penimbangan dan Pelarutan
- Timbang bubuk MacConkey Agar sebanyak ± 50 gram (sesuaikan dengan label kemasan, biasanya berkisar 48,5 gr – 52 gr per liter).
- Masukkan bubuk ke dalam Erlenmeyer berukuran 2 liter untuk mencegah meluap saat pemanasan.
- Tambahkan sedikit aquades terlebih dahulu untuk membilas sisa bubuk di dinding Erlenmeyer, lalu tambahkan sisa aquades hingga mencapai volume 1000 ml.
- Panaskan di atas hot plate sambil diaduk (bisa manual atau menggunakan magnetic stirrer).
- Penting: Pastikan larutan mendidih sempurna (biasanya sekitar 1 menit setelah titik didih tercapai) hingga media terlihat jernih dan tidak ada butiran agar yang tersisa. Jangan sampai gosong (overheating).
- Cek pH media sebelum sterilisasi (target pH umumnya 7.1 ± 0.2 pada suhu 25°C).
2. Sterilisasi
- Tutup mulut Erlenmeyer dengan kapas berbalut kasa, lalu lapisi dengan aluminium foil atau kertas payung.
- Masukkan ke dalam autoklaf.
- Sterilisasi pada suhu 121°C dengan tekanan 1 atm (15 lbs) selama 15 menit.
3. Penuangan (Plating)
- Keluarkan media dari autoklaf dan dinginkan hingga suhu sekitar 45-50°C (suhu di mana erlenmeyer masih bisa dipegang tangan tapi agar belum memadat). Mendinginkan media penting untuk mencegah kondensasi uap air berlebih di tutup cawan petri.
- Bekerjalah secara aseptis di dekat api bunsen atau di dalam Laminar Air Flow (LAF).
- Homogenkan media dengan menggoyangkan Erlenmeyer secara perlahan sebelum tuang.
- Tuang sekitar 15-20 ml media ke dalam cawan petri steril.
- Biarkan memadat pada suhu ruang.
- Simpan media secara terbalik di dalam kulkas (suhu 2-8°C) jika tidak langsung digunakan.
Cara Membaca Hasil (Interpretasi)
Setelah media ditanami bakteri dan diinkubasi (biasanya 37°C selama 24 jam), berikut cara mengidentifikasi koloni yang tumbuh:
- Laktosa Fermenter (Positif): Koloni akan berwarna merah muda (pink) hingga merah bata. Kadang dikelilingi zona endapan merah (presipitasi garam empedu). Bakteri menghasilkan asam dari laktosa, menurunkan pH, dan membuat indikator Neutral Red berubah merah. Contoh: Escherichia coli, Klebsiella, Enterobacter.
- Non-Laktosa Fermenter (Negatif): Koloni akan berwarna transparan, tidak berwarna, atau kekuningan (mengikuti warna dasar media). Bakteri tidak memfermentasi laktosa, sehingga pH tidak turun. Contoh: Salmonella, Shigella, Proteus, Pseudomonas.
Tips Anti-Gagal
Kegagalan paling umum dalam pembuatan MCA adalah media yang terlalu gelap (gosong) atau terlalu banyak uap air. Pastikan jangan memanaskan media terlalu lama setelah mendidih karena dapat merusak kandungan laktosa. Selain itu, penuangan media yang masih terlalu panas akan menyebabkan embun di tutup cawan petri yang bisa menetes dan merusak koloni bakteri nantinya.
Daftar Pustaka
- BD (Becton, Dickinson and Company). (2009). Difco™ & BBL™ Manual: Manual of Microbiological Culture Media. 2nd Edition. Sparks, MD: BD Diagnostics Systems.
- Cappuccino, J. G., & Welsh, C. (2018). Microbiology: A Laboratory Manual. 11th Edition. Pearson Education.
- Ziedan, A., Al-Hussaini, R., & Al-Jurayyan, N. (2018). The efficiency of MacConkey agar in the isolation of Gram-negative bacteria from clinical specimens. Journal of Health Specialties, 6(1), 32-36.